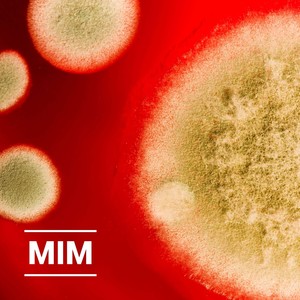
Colony

Mark in Me
热门歌曲
-
Поверхность SQ
Mark in Me 5.03 MB 05:29
-
Mark in Me 3.45 MB 03:46
-
Mark in Me 4.78 MB 05:12
-
Mark in Me 4.56 MB 04:58
-
Mark in Me 6.56 MB 07:09
-
Mark in Me 8.25 MB 09:00
-
Mark in Me 5.81 MB 06:20
-
Mark in Me 6.64 MB 07:15
-
Mark in Me 5.49 MB 06:00
-
Mark in Me 4.56 MB 04:58
-
Mark in Me 3.56 MB 03:53
-
Mark in Me 3.7 MB 04:02
-
Colony SQ
Mark in Me 6.56 MB 07:09
-
Mark in Me 5.97 MB 06:31
-
Mark in Me 4.68 MB 05:06
-
Mark in Me 4.76 MB 05:12
-
Mark in Me 3.63 MB 03:57
-
Mark in Me 6.7 MB 07:18
-
Mark in Me 4.91 MB 05:22
-
Mark in Me 5.68 MB 06:11
-
Mark in Me 4.68 MB 05:06
-
Mark in Me 7.17 MB 07:49
-
Mark in Me 5.93 MB 06:28
-
Mark in Me 4.65 MB 05:04
-
Mark in Me 2.44 MB 02:39
-
Mark in Me 4.29 MB 04:40
-
Mark in Me 6.94 MB 07:34